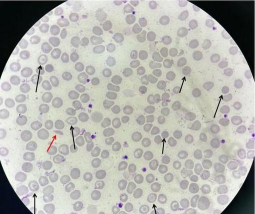

马的红细胞
红细胞的主要功能是将细胞代谢所需的氧气输送到组织。氧分子附着在称为血红蛋白的载体分子上,血红蛋白是红细胞中含铁的蛋白质,使细胞呈红色。氧气从肺部携带,并通过红细胞内的血红蛋白输送到所有身体组织。细胞利用氧气产生身体所需的能量。在这个过程中,二氧化碳作为废品被留下。然后,红细胞将二氧化碳从组织中带走,并带回肺部,在那里被呼出。当红细胞数量过少时,这被称为贫血。红细胞过少意味着血液携带的氧气较少。结果是疲劳和虚弱。当红细胞数量过高时,这被称为红细胞增多症。结果是血液会变得太稠,损害心脏向全身输送氧气的能力。动物的新陈代谢是为了保护红细胞和血红蛋白免受损伤。干扰血红蛋白的形成或释放、红细胞的产生或存活或其代谢会导致疾病。
健康动物的红细胞总数随时间保持不变。成熟的红细胞寿命有限;必须谨慎地平衡它们的产生和破坏,否则疾病就会发展。
红细胞的产生始于骨髓中的干细胞,结束于成熟红细胞释放到身体循环中。在骨髓中,所有的血细胞都始于一种称为干细胞的细胞。干细胞产生红细胞、白细胞或血小板生成细胞的未成熟形式。然后,未成熟的细胞再次分裂,进一步发育,最终成为成熟的红细胞、白细胞或血小板。
血细胞的生成速度取决于身体的需求。促红细胞生成素是一种由肾脏产生的激素,可刺激骨髓中红细胞的发育。如果身体缺氧,促红细胞生成素就会增加。在大多数物种中,肾脏既是决定身体组织接收多少氧气的传感器器官,也是促红细胞生成素产生的主要部位;因此,慢性肾功能衰竭会导致贫血。促红细胞生成素在决定是否增加进入红细胞生产的干细胞数量、缩短红细胞的成熟时间或引起红细胞的早期释放方面起着重要作用。影响红细胞生成的其他因素是营养物质的供应以及有助于其生成的化合物之间的细胞间相互作用。
贫血可能是由失血、红细胞破坏或产量减少引起的。在严重失血性贫血中,红细胞会丢失,但死亡通常是由于总血容量的减少,而不是由于红细胞丢失引起的缺氧。红细胞可能会被红枫叶等毒素、马传染性贫血等感染以及吩噻嗪类镇静剂等药物破坏。新生小马驹的溶血病是由母体对小马驹红细胞的抗体引起的。
红细胞生成减少可能是由原发性骨髓疾病、肾功能衰竭、毒素或苯丁氮酮等药物引起的。长期衰弱性疾病也可能与轻度贫血有关。重要的是要记住,贫血是一种临床发现,而不是一种特定的诊断。预后和治疗取决于根本原因。
金边虎皮兰喜欢什么土质
金边虎皮兰对土壤的要求以疏松透气、排水良好且富含有机质为最佳,以下是具体建议及注意事项:腐叶土+园土+河沙:可按3:2:3的比例混合,腐叶土提供有机质,园土保肥,河沙增强透气性。沙土+腐殖土+园土:比例为2:3:2,适合提升透气性和肥力,需
· 2025-11-05
马的日常保健
除了正确喂养和锻炼你的马外,还需要其他方面的一般护理来保持你的马一生健康。这些包括疫苗接种、寄生虫控制和牙科护理的常规兽医护理;仪容整洁和蹄部护理;以及对元素的保护。兽医护理的重要性成年马应至少每年进行一次全面的兽医检查。老年马应每年两次或
· 2025-11-05
荷花怎么种植家庭
家庭种植荷花需注意容器选择、土壤处理、种植方法及养护管理,具体要点如下:容器要求选择直径30-60厘米、无排水孔的花盆或水缸,底部可铺砖石降低深度(避免水深过大导致根系缺氧)。原生塘泥是最佳选择,可直接挖取荷塘淤泥,富含有机质且透气性好。土
· 2025-11-05
挑选一匹马
选择合适的马需要时间,而且可能很困难。马有许多不同的大小、品种、颜色、气质和健康状况。所有这些都应该考虑在内,同时要记住马的使用方式以及骑手在马周围的技能和舒适度。品种、气质和用途在美国,常见的马和小马品种有150多种。体型从大型役用品种,
· 2025-11-05
大豆病虫害的防治方法
大豆是重要的粮食和油料作物,其产量和品质直接影响到农业经济效益和粮食安全。在大豆的生长过程中,病虫害是影响产量和品质的主要因素之一。那么,大豆病虫害的防治方法是什么呢?下面,一起来看看吧!大豆病虫害的防治方法1、黄叶病(1)发病症状黄叶病是
· 2025-11-05
马的牙齿和口腔
与狗和猫不同,马是草食动物,专门吃谷物和草。口腔前部的切牙用于抓草和切割草,而后臼齿和前臼齿则用于研磨。马的牙齿在一生中不断生长——随着牙冠被磨平,新的替代材料从颌骨中产生。马有24颗乳牙;这些牙齿被40至42颗恒牙所取代,这些恒牙在6个月
· 2025-11-05
马的描述和身体特征介绍
马已经进化了数百万年,从狗大小的动物进化到今天的更大的动物。它们与人类联系的起源尚不清楚,但有证据表明,它们最早是在公元前2000年左右被中东游牧部落驯化的,甚至更早的时候被中国人驯化。与作为捕食者的狗和猫不同,马是猎物。它们以谷物和草为食
· 2025-11-05
宠物鸟的伤害和事故
宠物鸟天生渴望隐藏任何疾病或伤害。在野外,出现疾病迹象会增加它们被其他动物攻击的机会。因此,任何异常的行为都表明你的鸟可能生病了。特别是,如果你发现跛行、无法正确移动翅膀、任何异常分泌物、粪便的任何变化或普遍缺乏身体活动,你应该及时寻求兽医
· 2025-11-05
如何在家养小龙虾
小龙虾因美味和营养价值,近年来成为家庭餐桌上的必备食材。在家中养殖小龙虾不仅能满足日常饮食需求,还能带来养殖的乐趣和成就感。那么,如何在家养小龙虾呢?下面,将为大家详细解答在家养殖小龙虾的方法。如何在家养小龙虾一、养殖环境1、养殖容器:龙虾
· 2025-11-05
如何有效治疗番茄青枯病
番茄青枯病是番茄种植过程中常见且危害严重的细菌性病害。该病发病迅速,传播快,一旦发生,往往导致植株快速萎蔫、死亡,严重影响番茄的产量和品质。那么,如何有效治疗番茄青枯病呢?下面,一起来看看吧!如何有效治疗番茄青枯病1、农业防治选择抗病品种:
· 2025-11-05